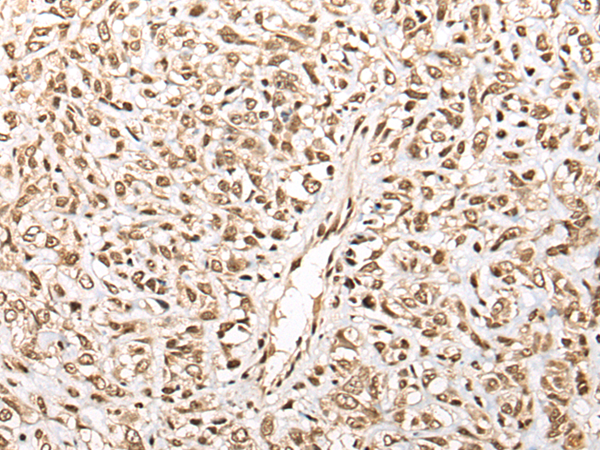

中文名稱:兔抗BTK多克隆抗體
|
Background: |
The protein encoded by this gene plays a crucial role in B-cell development. Mutations in this gene cause X-linked agammaglobulinemia type 1, which is an immunodeficiency characterized by the failure to produce mature B lymphocytes, and associated with a failure of Ig heavy chain rearrangement. Alternative splicing results in multiple transcript variants encoding different isoforms. |
|
Applications: |
ELISA, IHC |
|
Name of antibody: |
BTK |
|
Immunogen: |
Fusion protein of human BTK |
|
Full name: |
Bruton tyrosine kinase |
|
Synonyms: |
AT; ATK; BPK; XLA; IMD1; AGMX1; PSCTK1 |
|
SwissProt: |
Q06187 |
|
ELISA Recommended dilution: |
5000-10000 |
|
IHC positive control: |
Human lung cancer and human brain |
|
IHC Recommend dilution: |
25-100 |

購物車
幫助
021-54845833/15800441009
